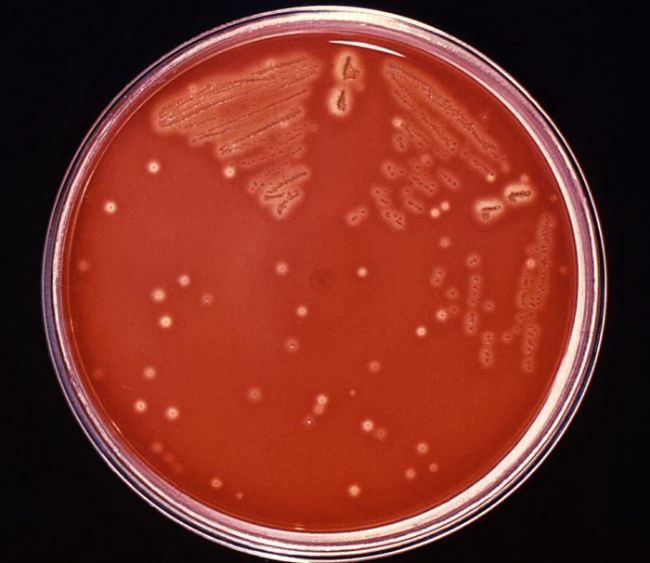
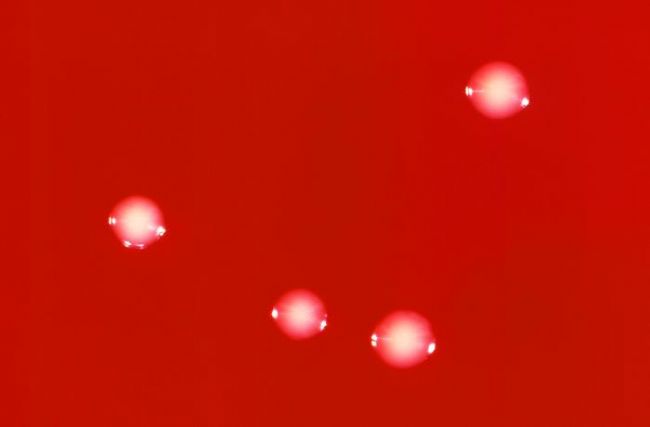

培養基觀察法和顯微鏡檢查法觀察鏈球菌的形態
顯微鏡下的鏈球菌|應用百科
鏈球菌是化膿性球菌的另一類常見細菌,廣泛存在于自然界和人及動物糞便和健康人鼻咽部,大多數為正常菌群,并不致病,但部分鏈球菌可引起多種疾病,主要分為感染性疾病和變態反應性疾病兩大類。那么鏈球菌到底長什么樣子?可以采用培養基和顯微鏡檢查法。
一、培養基

血瓊脂平板上形成灰白色、有乳光、表面光滑,邊緣整齊、直徑0.5—0.75mm的細小菌落。
二、顯微鏡檢查法
顯微鏡檢查法是通過直接觀察樣本中細菌的形態、排列等特征來進行鑒定的方法。檢驗人員會采集患者的痰液、血液或腦脊液等樣本,經過適當處理后,在顯微鏡下觀察。

在顯微鏡下的形態是球形或卵圓形,直徑0.6~1.0um,多數呈鏈狀排列,經革蘭氏染色后,顯微鏡下呈紫色。

如果想高效觀察鏈球菌,還可以使用熒光顯微鏡,經熒光染色后,可見高特異性熒光反應,鏈球菌呈綠色熒光

鏈球菌是一種在顯微鏡下具有特定形態的革蘭氏陽性菌,其分類復雜且具有較強的致病性。通過顯微鏡檢查法可以初步鑒定鏈球菌感染,但確診還需結合其他實驗室檢查。預防和治療鏈球菌感染需要綜合措施,包括個人衛生、鍛煉、飲食、接種疫苗和藥物治療等。
如果您對顯微鏡感興趣或有疑問,歡迎與我們聯系,期待與您相約!
免責聲明
本站無法鑒別所上傳圖片、字體或文字內容的版權,如無意中侵犯了哪個權利人的知識產權,請來信或來電告之,本站將立即予以刪除,謝謝。
來源:http://www.mshot.com.cn/kehuanli/20250122.html,轉載請保留出處,謝謝!
Copyright(C) 1998-2025 生物器材網 電話:021-64166852;13621656896 E-mail:info@bio-equip.com






